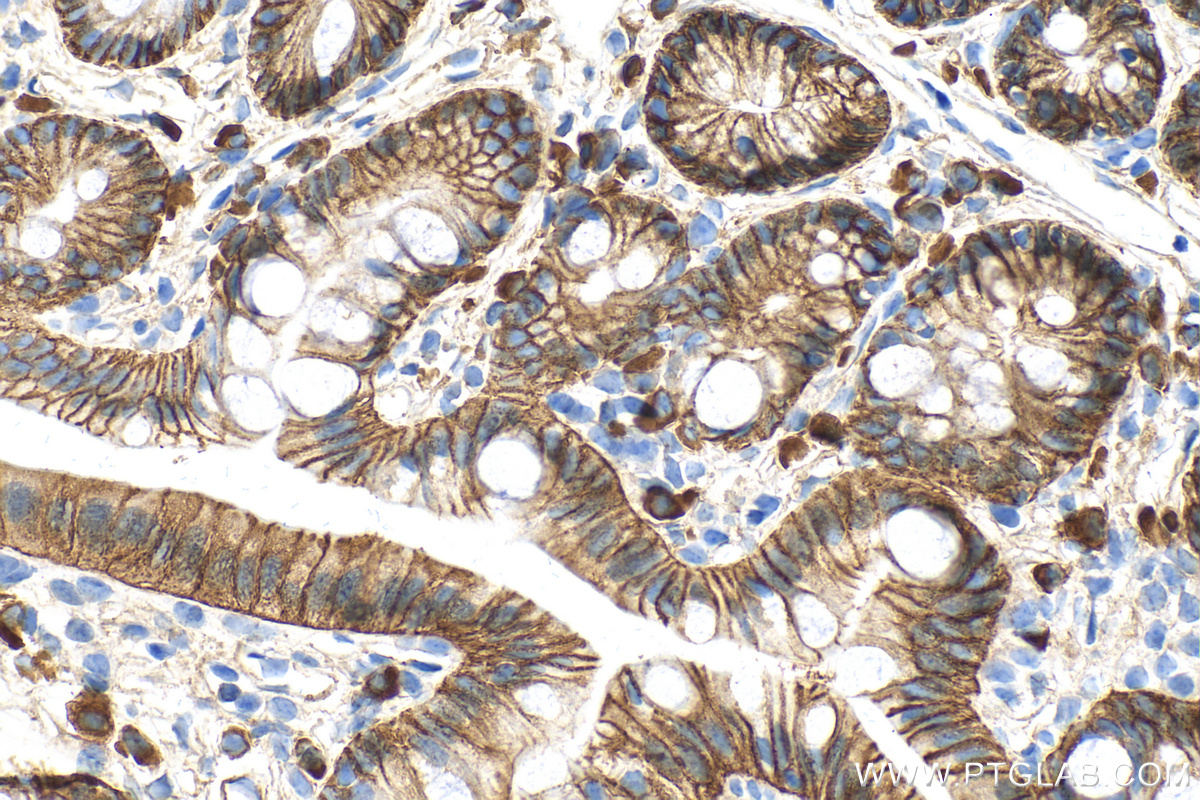
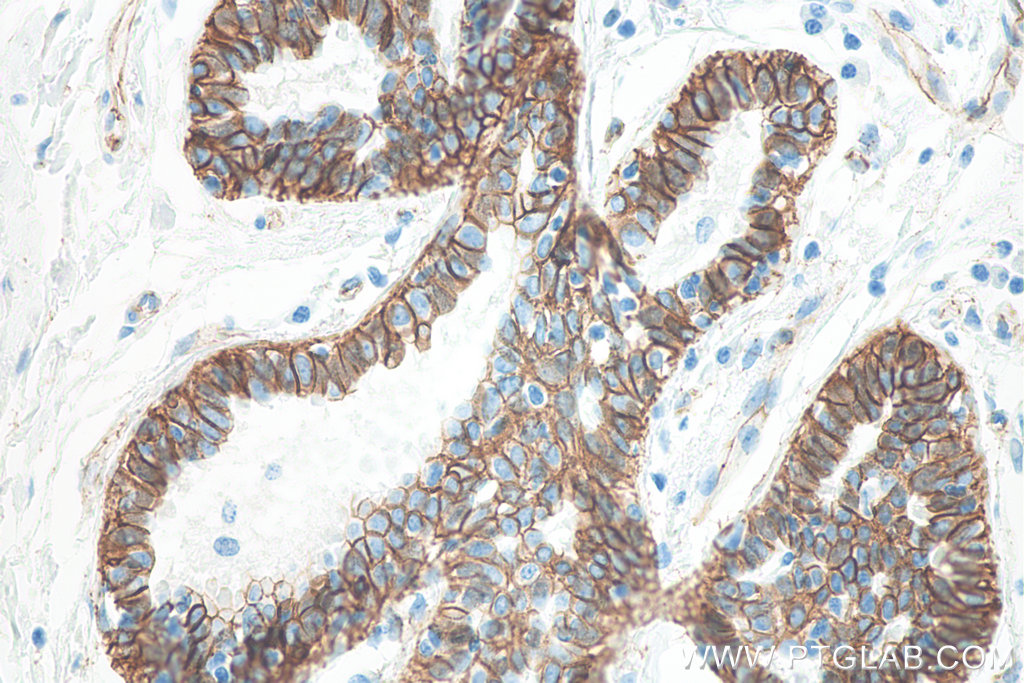
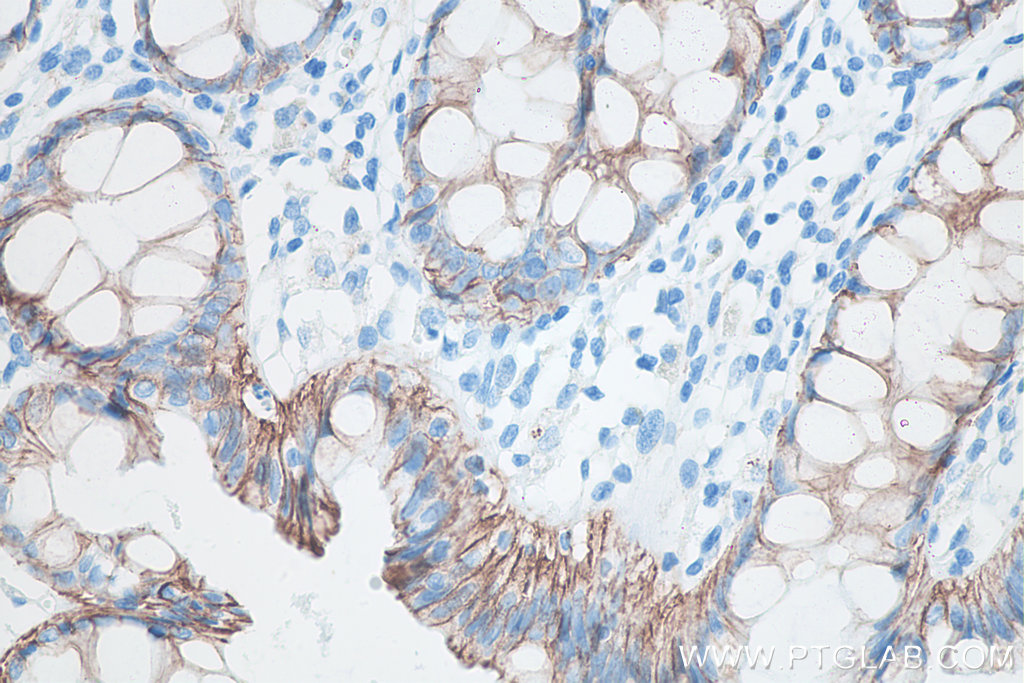

验证数据展示
经过测试的应用
| Positive WB detected in | A431 cells, pig brain tissue, rat brain tissue, mouse brain tissue, HeLa cells, HEK-293 cells, MCF-7 cells, LNCaP cells, HSC-T6 cells, NIH/3T3 cells, rabbit brain tissue |
| Positive IP detected in | mouse brain tissue |
| Positive IHC detected in | mouse colon tissue, human breast cancer tissue, human colon tissue, human ovary cancer tissue, human skin cancer tissue, rat colon tissue Note: suggested antigen retrieval with TE buffer pH 9.0; (*) Alternatively, antigen retrieval may be performed with citrate buffer pH 6.0 |
| Positive IF-P detected in | human colon cancer tissue, human skin cancer tissue |
| Positive IF/ICC detected in | MCF-7 cells, human liver cancer tissue, human skin cancer tissue |
| Positive FC (Intra) detected in | MCF-7 cells |
推荐稀释比
| 应用 | 推荐稀释比 |
|---|---|
| Western Blot (WB) | WB : 1:5000-1:50000 |
| Immunoprecipitation (IP) | IP : 0.5-4.0 ug for 1.0-3.0 mg of total protein lysate |
| Immunohistochemistry (IHC) | IHC : 1:10000-1:40000 |
| Immunofluorescence (IF)-P | IF-P : 1:200-1:800 |
| Immunofluorescence (IF)/ICC | IF/ICC : 1:750-1:3000 |
| Flow Cytometry (FC) (INTRA) | FC (INTRA) : 0.50 ug per 10^6 cells in a 100 µl suspension |
| It is recommended that this reagent should be titrated in each testing system to obtain optimal results. | |
| Sample-dependent, Check data in validation data gallery. | |
产品信息
66379-1-Ig targets Beta Catenin in WB, IHC, IF/ICC, IF-P, FC (Intra), IP, CoIP, ELISA applications and shows reactivity with human, mouse, rat, pig samples.
| 经测试应用 | WB, IHC, IF/ICC, IF-P, FC (Intra), IP, ELISA Application Description |
| 文献引用应用 | WB, IHC, IF, IP, CoIP |
| 经测试反应性 | human, mouse, rat, pig |
| 文献引用反应性 | human, mouse, rat, pig, chicken, sheep |
| 免疫原 |
Peptide 种属同源性预测 |
| 宿主/亚型 | Mouse / IgG1 |
| 抗体类别 | Monoclonal |
| 产品类型 | Antibody |
| 全称 | catenin (cadherin-associated protein), beta 1, 88kDa |
| 别名 | 1B8A1, b cat, B-catenin, beta-Catenin, Catenin beta 1 |
| 计算分子量 | 781 aa, 86 kDa |
| 观测分子量 | 92 kDa |
| GenBank蛋白编号 | NM_001904 |
| 基因名称 | Beta Catenin |
| Gene ID (NCBI) | 1499 |
| ENSEMBL Gene ID | ENSG00000168036 |
| RRID | AB_2857358 |
| 偶联类型 | Unconjugated |
| 形式 | Liquid |
| 纯化方式 | Protein G purification |
| UNIPROT ID | P35222 |
| 储存缓冲液 | PBS with 0.02% sodium azide and 50% glycerol, pH 7.3. |
| 储存条件 | Store at -20°C. Stable for one year after shipment. Aliquoting is unnecessary for -20oC storage. |
背景介绍
β-Catenin, also known as CTNNB1, is an evolutionarily conserved, multifunctional intracellular protein. β-Catenin was originally identified in cell adherens junctions (AJs) where it functions to bridge the cytoplasmic domain of cadherins to a-catenin and the actin cytoskeleton. Besides its essential role in the AJs, β-catenin is also a key downstream component of the canonical Wnt pathway that plays diverse and critical roles in embryonic development and adult tissue homeostasis. The Wnt/β-catenin pathway is also involved in the activation of other intracellular messengers such as calcium fluxes, JNK, and SRC kinases. Deregulation of β-catenin activity is associated with multiple diseases including cancers. (PMID: 22617422; 18334222)
实验方案
| Product Specific Protocols | |
|---|---|
| FC protocol for Beta Catenin antibody 66379-1-Ig | Download protocol |
| IF protocol for Beta Catenin antibody 66379-1-Ig | Download protocol |
| IHC protocol for Beta Catenin antibody 66379-1-Ig | Download protocol |
| IP protocol for Beta Catenin antibody 66379-1-Ig | Download protocol |
| WB protocol for Beta Catenin antibody 66379-1-Ig | Download protocol |
| Standard Protocols | |
|---|---|
| Click here to view our Standard Protocols |
发表文章
| Species | Application | Title |
|---|---|---|
Adv Mater Noninvasive Optogenetics Realized by iPSC-Derived Tentacled Carrier in Alzheimer's Disease Treatment | ||
Nat Commun Cholecystectomy-related gut microbiota dysbiosis exacerbates colorectal tumorigenesis | ||
Acta Pharm Sin B Protocatechuic aldehyde protects cardiomycoytes against ischemic injury via regulation of nuclear pyruvate kinase M2. | ||
J Exp Clin Cancer Res Membrane RRM2-positive cells represent a malignant population with cancer stem cell features in intrahepatic cholangiocarcinoma
| ||
Research (Wash D C) The Mechanics of Tumor Cells Dictate Malignancy via Cytoskeleton-Mediated APC/Wnt/β-Catenin Signaling | ||
Acta Biomater Microenvironmental reprogramming of human dermal papilla cells for hair follicle tissue engineering |